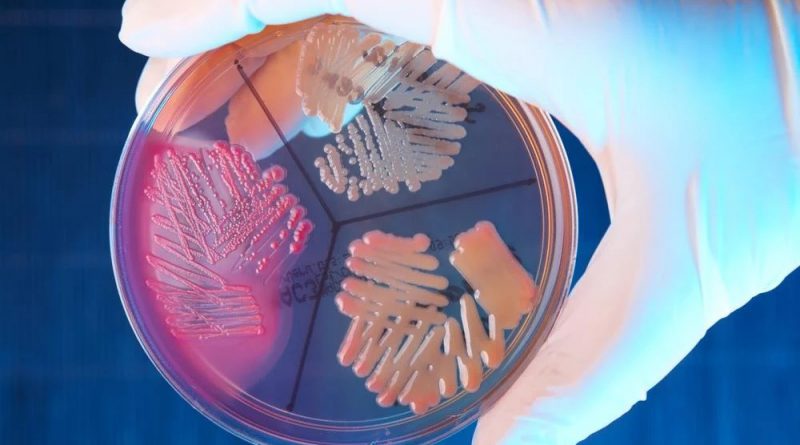

Ανακαλύφθηκαν γιγάντιοι ιοί ηλικίας 1,5 δισ. ετών
Γιγάντιοι ιοί που χρονολογούνται πριν από 1,5 δισεκατομμύρια χρόνια εντοπίστηκαν στις γεωθερμικές πηγές του Εθνικού πάρκου Γιέλοουστόουν στις ΗΠΑ. Πρόκειται για ένα μοναδικό τεράστιας έκτασης πάρκο που είναι γνωστό για την άγρια ζωή που φιλοξενεί και τα πολλά γεωθερμικά χαρακτηριστικά του, ειδικά τα γκέιζερ.
Ερευνητική ομάδα με επικεφαλής επιστήμονες στο Πανεπιστήμιο Rutgers στις ΗΠΑ εντόπισε στις γεωθερμικές πηγές του Γιελοουστόουν γιγάντιους ιούς που χρονολογούνται πριν από 1,5 δισεκατομμύρια χρόνια. Με δημοσίευση τους στην επιθεώρηση «Communications Biology» οι ερευνητές αναφέρουν ότι η ανακάλυψη θα μπορούσε να αποκαλύψει τις συνθήκες υπό τις οποίες σχηματίστηκε η ζωή στη Γη.
Οι ιοί χαρακτηρίζονται ως «γίγαντες» επειδή έχουν εξαιρετικά μεγάλα γονιδιώματα σε σύγκριση με τους κανονικούς ιούς και δεν αποτελούν κίνδυνο για τον άνθρωπο, αλλά θα μπορούσαν να εξηγήσουν πώς ήταν οι συνθήκες στη Γη όταν σχηματίστηκαν μονοκύτταροι οργανισμοί. Οι ερευνητές ανακάλυψαν ότι ορισμένοι ιοί αποτελούνταν από βακτήρια, ενώ άλλοι ανήκαν στους αποκαλούμενους Αρχαίους, έναν μονοκύτταρο οργανισμό παρόμοιο με τα βακτήρια που απαιτεί ακραία περιβάλλοντα για να αναπαραχθεί. Κάποιοι ιοί ανήκουν στους ευκαρυωτικούς που βρίσκονται στους μύκητες.
Οι θεωρίες
Όλες οι θεωρίες μέχρι σήμερα για την εξέλιξη της ζωής στη Γη συνέκλιναν ότι οι ιοί έχουν κατά πολύ νεότερη ηλικία από αυτή που υποδεικνύει η νέα ανακάλυψη επειδή οι θερμές πηγές (αν θεωρήσουμε ότι αποτελούν επίκεντρο παρουσίας της ζωής) έρχονται και παρέρχονται με την πάροδο του χρόνου.
Όμως η νέα μελέτη δείχνει ότι υπάρχουν ιοί στον πλανήτη με ηλικία παρόμοια με αυτή των κυτταρικών οργανισμών.
Αρχικά, οι ερευνητές πίστευαν ότι οι γιγάντιοι ιοί που εντόπισαν δεν θα ήταν ιδιαίτερα μεγάλοι σε ηλικία, επειδή καθώς οι θερμές πηγές σχηματίζονται και εξαφανίζονται οι ιοί θα έπρεπε να ξανασχηματιστούν κάτω από υψηλότερες θερμοκρασίες στην πρόσφατα αναπτυγμένη θερμή πηγή.
Οι θερμές πηγές βρίσκονται σε αδρανοποιημένα ηφαίστεια το μάγμα των οποίων θερμαίνει τα υπόγεια ύδατα προκαλώντας τον ατμό και το λιγότερο πυκνό ζεστό νερό να ανέβει μέσα από τις ρωγμές στη γη, δημιουργώντας θερμοπίδακες και θερμές πηγές.
Οι θερμές πηγές του Γιελοουστόουν σχηματίστηκαν πριν από τουλάχιστον 15.000 χρόνια μετά την τήξη των τελευταίων παγετώνων στην περιοχή, επιτρέποντας στους θερμοπίδακες να ξεπηδήσουν αλλά οι ιοί σύμφωνα με τους ερευνητές ευδοκιμούσαν για περισσότερα από ένα δισεκατομμύριο χρόνια πριν.
Naftemporiki.gr